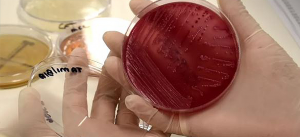
Estudo aponta milhões de bactérias e fungos em moscas formigas e baratas

Atendimento em São Paulo e Campinas
- Sobre
- Desentupimento
- Dedetização
- Dedetização contra Dengue em São Paulo e ABC | Aedes Controle – Império
- Dedetização de Aranhas em São Paulo
- Dedetização de Baratas em São Paulo
- Dedetização de Carrapatos em São Paulo
- Dedetização de Escorpião em São Paulo
- Dedetização de formigas em São Paulo
- Dedetização de Lacraias em São Paulo
- Dedetização de Lesmas em São Paulo
- Dedetização de Moscas em São Paulo
- Dedetização de Mosquitos e Pernilongos em São Paulo
- Dedetização de Pulgas em São Paulo
- Dedetização de Traças em São Paulo
- Sanitização de Ambientes em São Paulo
- Dedetização ou Desinsetização (Controle de Pragas)
- Mais serviços
- Conteúdos